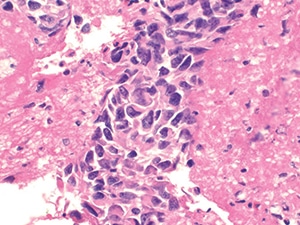

Muhammad Ahmed, MD
He Wang, MD, PhD
January 2023—In recent years, a standardized classification system for the cytology of serous body cavities has been proposed. The system, known as the International System for Reporting Serous Fluid Cytopathology (ISRSFC), published by Ashish Chandra, et al., 1 in 2020, aims to enhance the reproducibility of cytologic diagnoses, thereby facilitating clearer communication with clinicians. The diagnostic categories are as follows: I. Non-Diagnostic; II. Negative for Malignancy; III. Atypia of Undetermined Significance; IV. Suspicious for Malignancy; V. Malignant. Each progressive diagnostic category from I through V carries with it an increasing risk of malignancy (Table 1). This brief review article aims to highlight the salient points of each diagnostic category and includes discussion of recent publications and our own institutional experience.

I. Non-Diagnostic (ND). This category is used for those specimens that are either too paucicellular to interpret or have other issues precluding accurate assessment, such as poor preservation, obscuring blood (Fig. 1), and poor processing.
II. Negative for Malignancy (NFM). This is the most commonly used category (approximately 70 to 80 percent of cases). The specimen does not reveal any morphologic evidence of mesothelial or non-mesothelial malignancy. The specimen essentially consists of the normal constituents of serous fluid: mesothelial cells, lymphocytes, and macrophages and/or serositis (Fig. 2).
III. Atypia of Undetermined Significance (AUS). This is an indeterminate category where the specimen lacks either quantitative or qualitative features of malignancy. Malignancies with bland cytomorphology in addition to degenerated cells and cells more closely resembling reactive atypia may fall under this category (Fig. 3). Pericardial and peritoneal fluids have a higher incidence of this category as compared with pleural fluids.

IV. Suspicious for Malignancy (SFM). Specimens that have cytomorphologic features compatible with malignancy but are either quantitatively or qualitatively insufficient for a definitive diagnosis of malignancy fall into this category (Figs. 4–6). Cases with concurrent surgical follow-up with malignant findings may be placed into the malignant category (see below). Most cases in the AUS or SFM category are classified as such due to low cellularity of malignant cells and/or low volume of fluid analyzed. Most patients have a prior history of malignancy or have malignant findings on surgical follow-up.
V. Malignant (MAL). Specimens with findings that are unequivocal for malignancy either alone or with concomitant ancillary testing are placed in this category (Figs. 7–10). The cell of origin must be identified to the furthest extent possible. New diagnostic criteria for the diagnosis of malignant mesothelial proliferations are discussed next.

Diagnostic criteria for mesothelioma. The diagnosis of mesothelioma is one of the most challenging on cytology alone. The clinical history and radiologic findings must always be taken into consideration. New diagnostic criteria have emerged for discerning malignant mesothelial proliferations from reactive ones. In patients with a compatible clinical and radiologic history, immunocytochemistry for BRCA-associated protein 1 (BAP-1) has been shown to be lost in the majority of malignant mesothelial proliferations (Figs. 11 and 12) when taken in conjunction with atypical cytomorphology (i.e. extremely hypercellular specimen containing cells with overt nuclear abnormalities, cellular spheres, papillary tissue fragments, morulae, or single cells). If BAP-1 is retained (nuclear staining), fluorescent in situ hybridization for p16 may be used. If the findings show loss of p16, the findings are also compatible with a mesothelioma in the appropriate clinical setting. If there is no deletion of p16, a malignant mesothelial proliferation cannot be excluded. Interestingly, sarcomatoid mesothelioma shows loss of p16 in 90 to 100 percent of cases while the epithelioid and biphasic variants show loss in only about 70 percent of cases. BAP-1 has low sensitivity (approximately 56 percent) but very high specificity (approximately 100 percent).




General diagnosis. In our experience, when compelling atypical cells are present in serous fluids, we opt to use two epithelial markers and two mesothelial markers on immunocytochemistry. At our institution, we use calretinin and cytokeratin 5/6 as our mesothelial markers and MOC31 and Ber-Ep4 as our epithelial markers. Depending on the type of malignancy suspected, we may opt to use other mesothelial markers such as WT-1 or D2-40 since certain malignancies such as squamous cell carcinoma may be positive for cytokeratin 5/6. The new antibody, claudin-4, is also used depending on cytopathologist preference and the degree of suspicion for malignancy. If the epithelial markers are positive, additional immunocytochemistry is added to further delineate the cell of origin. If atypical lymphoid cells are present, correlation with concurrent flow cytometry results is warranted. If there is no concurrent flow cytometry and depending on how much specimen is left over, we may opt to add on CD3 and CD20 immunocytochemistry stains. B-cell or T-cell receptor clonality studies by molecular testing may also be ordered on the leftover specimen if immunocytochemistry is not a viable option (i.e. too few or scattered cells present to make a distinction between B and T cells). Mesenchymal tumors with recurrent molecular alterations are sent for molecular testing, if possible. Atypical mesothelial proliferations with clinical and radiologic findings concerning for mesothelioma are worked up according to the aforementioned new diagnostic criteria.




A word on pericardial and pleural effusions. Pericardial effusions are more likely to be malignant than other serous effusions, and they tend to show mesothelial cells with a greater degree of atypia and clustering than at other sites. Additionally, recent studies in our institute have shown that pericardial cytology has a higher sensitivity than pericardial biopsy in detecting malignancy in this cavity (77 percent and 53 percent, respectively).2 Thus, pericardial cytology plays an important role in the diagnosis of malignancy. At our institution, adenocarcinoma of the lung is the most common metastatic malignancy detected in both pericardial and pleural effusions. Curiously, the most common primary malignant tumor of the pericardium we’ve encountered in our cohort is angiosarcoma while the most common primary malignant tumor of the pleural cavity is mesothelioma (Figs. 13–16). Furthermore, although uncommon in serous effusions to begin with, hematolymphoid tumors more often involve the pericardium than the pleura.3 Larger cohort studies are needed to evaluate the variety of tumors that involve both of these cavities.

Peritoneal washing and ascites. A few differences between peritoneal/pelvic washings and ascites fluid must be taken into account (Table 2).
Recent studies of ISRSFC and our institutional experience. Publications assessing the feasibility and accuracy of the International System for Reporting Serous Fluid Cytology have shown overall positive results. A recent study by Ahuja, et al.,4 showed an incidence of each category and risk of malignancy comparable to that presented in the ISRSFC. Several other studies have shown similar results. Yale’s Sun, et al.,5 concluded from their study on pleural and peritoneal fluids, in a community-based hospital setting, that each hospital must determine its own institutional risk of malignancy based off its own use of ISRSFC categories. This is namely because the parameter may vary between the patient populations seen at large academic centers and smaller community hospitals.
Additionally, studies have shown decent interobserver agreement between the diagnostic categories, with the greatest concordance seen in NFM and MAL cases (76 percent and 81 percent, respectively).6 The categories of AUS and SFM showed poor interobserver agreement. The reason for this may lie in the subjectivity and experience of the cytopathologist in using one diagnostic category over another.
Conclusion. Overall, the ISRSFC appears to be a feasible classification system that standardizes communication of diagnostic categories to clinicians, thereby streamlining patient management decisions in a more reproducible way. It will be interesting to see to what extent cytopathologists embrace this system in the future and what modifications it will undergo as more data on its usage become available. For now, we embrace this new system with cautious optimism.


- Chandra A, Crothers B, Kurtycz D, Schmitt F, eds. The International System for Serous Fluid Cytopathology. Springer; 2020.
- Bearse M, Tang H, Chandler J, Wang H. Diagnostic yield for pericardial effusion is superior to that of pericardial biopsy. Submitted and accepted for the United States and Canadian Academy of Pathology Annual Conference 2023.
- Tang H, Chen C, Wang H. Landscape of primary and secondary tumors of the pericardium and pleura, a single institutional review. Submitted and accepted for the United States and Canadian Academy of Pathology Annual Conference 2023.
- Ahuja S, Malviya A. Categorisation of serous effusions using the International System for Reporting Serous Fluid Cytopathology and assessment of risk of malignancy with diagnostic accuracy. Cytopathology. 2022;33(2):176–184.
- Sun T, Wang M, Wang H. Risk of malignancy assessment of the International System for Reporting Serous Fluid Cytopathology: experience in a community hospital setting and comparison with other studies. Cancer Cytopathol. Published online Aug. 22, 2022. doi:10.1002/cncy.22638
- Layfield LJ, Yang Z, Vazmitsel M, Zhang T, Esebua M, Schmidt R. The international system for serous fluid cytopathology: interobserver agreement. Diagn Cytopathol. 2022;50(1):3–7.
Additional related sources: - Cibas ES, Ducatman BS. Cytology: Diagnostic Principles and Clinical Correlates. 4th ed. Elsevier; 2014. http://www.clinicalkey.com/dura/browse/bookChapter/3-s2.0-C20110071892. Accessed Oct. 31, 2022.
- Gokozan HN, Harbhajanka A, Lyden S, Michael CW. Root cause analysis of indeterminate diagnoses in serous fluids cytopathology. Diagn Cytopathol. 2021;49(5):633–639.
- Dipper A, Maskell N, Bibby A. Ancillary diagnostic investigations in malignant pleural mesothelioma. Cancers (Basel). 2021;13(13):3291.
- Pergaris A, Stefanou D, Keramari P, et al. Application of the International System for Reporting Serous Fluid Cytopathology with cytohistological correlation and risk of malignancy assessment. Diagnostics (Basel). 2021;11(12):2223.
- Pinto D, Chandra A, Crothers BA, Kurtycz DFI, Schmitt F. The International System for Reporting Serous Fluid Cytopathology—diagnostic categories and clinical management. J Am Soc Cytopathol. 2020;9(6):469–477.
Dr. Wang is associate professor of pathology at Yale University School of Medicine and a member of the CAP Cytopathology Committee. Dr. Ahmed is a cytopathology fellow at Yale University.